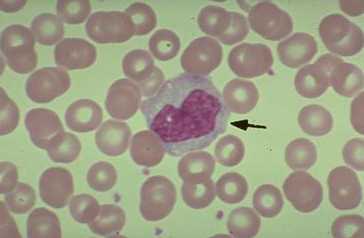
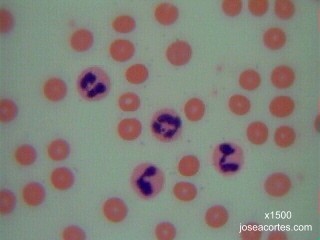

EL MICROSCOPIO
03.12.2009 17:05Aqui explicaremos las partes características del microscopio, como: su funcionamiento y prácticas que se pueden realizar con este mismo.
PARTES DE UN MICROSCOPIO ÓPTICO

- Sistema óptico
- OCULAR: Lente situada cerca del ojo del observador. Amplía la imagen del objetivo.
- OBJETIVO: Lente situada cerca de la preparación. Amplía la imagen de ésta.
- CONDENSADOR: Lente que concentra los rayos luminosos sobre la preparación.
- DIAFRAGMA: Regula la cantidad de luz que entra en el condensador.
- FOCO: Dirige los rayos luminosos hacia el condensador.
- Sistema mecánico
- SOPORTE: Mantiene la parte óptica. Tiene dos partes: el pie o base y el brazo.
- PLATINA: Lugar donde se deposita la preparación.
- CABEZAL: Contiene los sistemas de lentes oculares. Puede ser monocular, binocular, …..
- REVÓLVER: Contiene los sistemas de lentes objetivos. Permite, al girar, cambiar los objetivos.
- TORNILLOS DE ENFOQUE: Macrométrico que aproxima el enfoque y micrométrico que consigue el enfoque correcto.
MANEJO Y USO DEL MICROSCOPIO ÓPTICO
- Colocar el objetivo de menor aumento en posición de empleo y bajar la platina completamente. Si el microscopio se recogió correctamente en el uso anterior, ya debería estar en esas condiciones.
- Colocar la preparación sobre la platina sujetándola con las pinzas metálicas.
- Comenzar la observación con el objetivo de 4x (ya está en posición) o colocar el de 10 aumentos (10x) si la preparación es de bacterias.
- Para realizar el enfoque:
- Acercar al máximo la lente del objetivo a la preparación, empleando el tornillo macrométrico. Esto debe hacerse mirando directamente y no a través del ocular, ya que se corre el riesgo de incrustar el objetivo en la preparación pudiéndose dañar alguno de ellos o ambos.
- Mirando, ahora sí, a través de los oculares, ir separando lentamente el objetivo de la preparación con el macrométrico y, cuando se observe algo nítida la muestra, girar el micrométrico hasta obtener un enfoque fino.
- Pasar al siguiente objetivo. La imagen debería estar ya casi enfocada y suele ser suficiente con mover un poco el micrométrico para lograr el enfoque fino. Si al cambiar de objetivo se perdió por completo la imagen, es preferible volver a enfocar con el objetivo anterior y repetir la operación desde el paso 3. El objetivo de 40x enfoca a muy poca distancia de la preparación y por ello es fácil que ocurran dos tipos de percances: incrustarlo en la preparación si se descuidan las precauciones anteriores y mancharlo con aceite de inmersión si se observa una preparación que ya se enfocó con el objetivo de inmersión.
- Empleo del objetivo de inmersión:
- Bajar totalmente la platina.
- Subir totalmente el condensador para ver claramente el círculo de luz que nos indica la zona que se va a visualizar y donde habrá que echar el aceite.
- Girar el revólver hacia el objetivo de inmersión dejándolo a medio camino entre éste y el de x40.
- Colocar una gota mínima de aceite de inmersión sobre el círculo de luz.
- Terminar de girar suavemente el revólver hasta la posición del objetivo de inmersión.
- Mirando directamente al objetivo, subir la platina lentamente hasta que la lente toca la gota de aceite. En ese momento se nota como si la gota ascendiera y se adosara a la lente.
- Enfocar cuidadosamente con el micrométrico. La distancia de trabajo entre el objetivo de inmersión y la preparación es mínima, aun menor que con el de 40x por lo que el riesgo de accidente es muy grande.
- Una vez se haya puesto aceite de inmersión sobre la preparación, ya no se puede volver a usar el objetivo 40x sobre esa zona, pues se mancharía de aceite. Por tanto, si desea enfocar otro campo, hay que bajar la platina y repetir la operación desde el paso 3.
- Una vez finalizada la observación de la preparación se baja la platina y se coloca el objetivo de menor aumento girando el revólver. En este momento ya se puede retirar la preparación de la platina. Nunca se debe retirar con el objetivo de inmersión en posición de observación.
- Limpiar el objetivo de inmersión con cuidado empleando un papel especial para óptica. Comprobar también que el objetivo 40x está perfectamente limpio.
MANTENIMIENTO Y PRECAUCIONES
- Al finalizar el trabajo, hay que dejar puesto el objetivo de menor aumento en posición de observación, asegurarse de que la parte mecánica de la platina no sobresale del borde de la misma y dejarlo cubierto con su funda.
- Cuando no se está utilizando el microscopio, hay que mantenerlo cubierto con su funda para evitar que se ensucien y dañen las lentes. Si no se va a usar de forma prolongada, se debe guardar en su caja dentro de un armario para protegerlo del polvo.
- Nunca hay que tocar las lentes con las manos. Si se ensucian, limpiarlas muy suavemente con un papel de filtro o, mejor, con un papel de óptica.
- No dejar el portaobjetos puesto sobre la platina si no se está utilizando el microscopio.
- Después de utilizar el objetivo de inmersión, hay que limpiar el aceite que queda en el objetivo con pañuelos especiales para óptica o con papel de filtro (menos recomendable). En cualquier caso se pasará el papel por la lente en un solo sentido y con suavidad. Si el aceite ha llegado a secarse y pegarse en el objetivo, hay que limpiarlo con una mezcla de alcohol-acetona (7:3) o xilol. No hay que abusar de este tipo de limpieza, porque si se aplican estos disolventes en exceso se pueden dañar las lentes y su sujeción.
- No forzar nunca los tornillos giratorios del microscopio (macrométrico, micrométrico, platina, revólver y condensador).
- El cambio de objetivo se hace girando el revólver y dirigiendo siempre la mirada a la preparación para prevenir el roce de la lente con la muestra. No cambiar nunca de objetivo agarrándolo por el tubo del mismo ni hacerlo mientras se está observando a través del ocular.
- Mantener seca y limpia la platina del microscopio. Si se derrama sobre ella algún líquido, secarlo con un paño. Si se mancha de aceite, limpiarla con un paño humedecido en xilol.
- Es conveniente limpiar y revisar siempre los microscopios al finalizar la sesión práctica y, al acabar el curso, encargar a un técnico un ajuste y revisión general de los mismos.
DIFERENTES PRÁCTICAS QUE PODEMOS REALIZAR:
|
Observación de epidermis de cebolla |
||
|
MATERIAL
RESULTADOS El resultado de esta práctica debe ser semejante a lo que muestran las siguientes fotos obtenidas con microscopio óptico:
|
|
Observación de bacterias |
||||||||
BACTERIAS DEL YOGUR El yogur es un producto lácteo producido por la fermentación natural de la leche. A escala industrial se realiza la fermentación añadiendo a la leche dosis del 3-4% de una asociación de dos cepas bacterianas: el Streptococcus termophilus, poco productor de ácido, pero muy aromático, y el Lactobacillus bulgaricus, muy acidificante. En esta preparación se podrán, por tanto, observar dos morfologías bacterianas distintas (cocos y bacilos) y un tipo de agrupación (estreptococos, cocos en cadenas arrosariadas). Además, el tamaño del lactobacilo (unos 30µm de longitud) facilita la observación aunque no se tenga mucha práctica con el enfoque del microscopio.
BACTERIAS DEL VINAGRE El vinagre es una solución acuosa rica en ácido acético resultante de la fermentación espontánea del vino o de bebidas alcohólicas de baja graduación. La acetificación del vino es producida por bacterias aeróbicas del ácido acético, principalmente Acetobacter aceti, aunque también Gluconobacter. Se trata de bacilos rectos con flagelos polares.
BACTERIAS DEL SARRO DENTAL El sarro dental es un depósito consistente y adherente localizado sobre el esmalte de los dientes. Está constituido principalmente por restos proteicos, sales minerales y bacterias junto con sus productos metabólicos. La flora bacteriana de la cavidad bucal es muy variable dependiendo de las condiciones que se den en el momento de hacer la preparación, pero suelen abundar bacterias saprófitas, pudiéndose observar gran variedad de morfologías: espiroquetas, cocobacilos, diplococos y bacilos.
BACTERIAS DEL SUELO La variedad de bacterias que pueden aparecer en una muestra de suelo es prácticamente infinita, muchas de ellas no cultivables en los laboratorios y algunas, incluso, desconocidas para los microbiólogos. Para recoger la muestra y hacer el frotis basta con dejar parcialmente enterrado en vertical un portaobjetos en la tierra de una maceta o de un jardín. Después de varios días, las bacterias se habrán adherido al vidrio y sólo habrá que fijarlas por calor y teñirlas con un colorante cualquiera. Previamente hay que limpiar los bordes del portaobjetos, así como la parte que no se va a teñir. |
||||||||

morfologia_bacteriana.jpg (17,1 kB)
|
Observación microscópica de hongos |
||||||||||||
PREPARACIÓN EN FRESCO DE MOHOS
TÉCNICA
PREPARACIÓN EN CINTA ADHESIVA
TÉCNICA
|
||||||||||||
Francisco Javier Fílter Rull 1º BACHILLER
—————
Contacto
ISAÍAS COMICHE RIEGO =) ANTONIO LERMA MOLIZ =) ANDREA GÓMEZ GARCÍA =) FRANCISCO J. FILTER RULL =)1º BACHILLERATO A del IES Luís Vélez de Guevara (Écija-Sevilla
* Nuestro gmail es :
colegofi@gmail.com